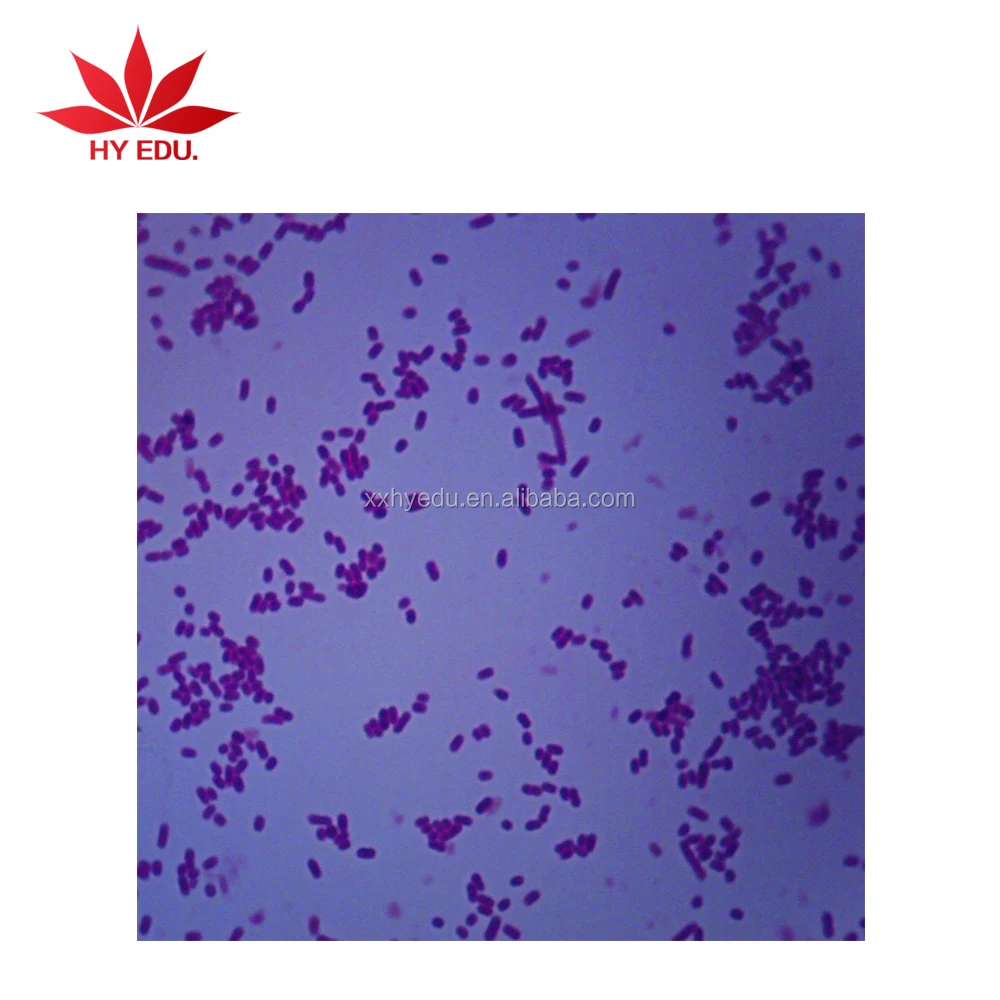
High quality bacteria prepared slides Prepared microbiology bacteria slide set laboratory accessories

Other Educational Supplies

1$ Children Toy Gift paper 200X 400X 1000X 2000X Foldscope
- Category:
- Supplier: Yongjia,Saiens,Trade,Co.,Ltd.
$2.85 - $3.02
In Stock

Rare Pink Thulite - Raw Natural Crystals for Wicca and Reiki Crystal Healing
- Category:
- Supplier: Xinxiang,Vic,Science,&,Education,Co.,Ltd.
In Stock

Laboratory Sperm Counting Chamber with Ruby
- Category:
- Supplier: Xinxiang,Vic,Science,&,Education,Co.,Ltd.,[Henan,China]Xinxiang
RUB 15,455.07 - RUB 21,422.86
In Stock

High Quality Acrylic Compass Map Scale Ruler Military Luminous Folding Glow Compass
- Category:
- Supplier: Shaoxing,Keqiao,Science,Instrument,Co.,Ltd.
RUB 81.76
In Stock

Human Tissue Slides Human Histology Slides Glass Slides
- Category:
- Supplier: Xinxiang,Vic,Science,&,Education,Co.,Ltd.
RUB 9,563.78
In Stock
High quality bacteria prepared slides Prepared microbiology bacteria slide set laboratory accessories
- Category:
- Supplier: Xinxiang,Hongye,Edu.,Instrument,Co.,Ltd.,[Henan,China]Xinxiang
RUB 22.96 - RUB 153.03
In Stock

Insect Collection Specimen of Honey Bee Life Cycle for Educational Toys Gift Customized
- Category:
- Supplier: Nanning,Benji,Biological,Technology,Co.,Ltd.,[Guangxi,China]Nanning
RUB 1,174.37 - RUB 1,397.35
In Stock

Student Rice leaf cutting glass microscope prepared slides
- Category:
- Supplier: Xinxiang,Vic,Science,&,Education,Co.,Ltd.,[Henan,China]Xinxiang
RUB 114.77 - RUB 1,530.21
In Stock

Fixed 24pcs of box set on Prepared Laboratory Rock Microscope Slides for Research
- Category:
- Supplier: Xinxiang,City,Voyage,Teaching,Equipment,Co.,Ltd.
RUB 13,006.74
In Stock

Testis enlarge model human medical science anatomy model
- Category:
- Supplier: Xinxiang,Vic,Science,&,Education,Co.,Ltd.,[Henan,China]Xinxiang
RUB 1,114.91 - RUB 2,973.09
In Stock

100 PCS Set biological microscope microslide hard bone prepared slides
- Category:
- Supplier: Xinxiang,Vic,Science,&,Education,Co.,Ltd.,[Henan,China]Xinxiang
RUB 4,385.30 - RUB 5,425.88
In Stock

Medical study embryology slides frog embryo slides prepared microscope slides
- Category:
- Supplier: Xinxiang,Vic,Science,&,Education,Co.,Ltd.,[Henan,China]Xinxiang
RUB 2,675.78 - RUB 4,459.63
In Stock

Pollen Gem W.M. prepared microscope botany slides for medical biology research microscope prepared slides
- Category:
- Supplier: Wuxi,Oceanedu,Import,And,Export,Co.,Ltd.,[Jiangsu,China]Wuxi
RUB 14.87 - RUB 22.30
In Stock

Best price good quality Mitochondria model
- Category:
- Supplier: Xinxiang,Vic,Science,&,Education,Co.,Ltd.,[Henan,China]Xinxiang
RUB 1,114.91 - RUB 5,202.90
In Stock

Studying Microscope Prepared Slides Histology Glass Slides Human Histology Tissue Slides
- Category:
- Supplier: Xinxiang,Vic,Science,&,Education,Co.,Ltd.,[Henan,China]Xinxiang
RUB 4,088.00 - RUB 5,202.90
In Stock

42 pcs Medical parasitological parasites microscopic slides
- Category:
- Supplier: Xinxiang,Hongye,Edu.,Instrument,Co.,Ltd.
RUB 11,892.34
In Stock

MONOCOT STEM, MAIZE, TS
- Category:
- Supplier: RADICAL,SCIENTIFIC,EQUIPMENTS,PRIVATE,LIMITED,[India]RADICAL
RUB 6,317.81
In Stock

Safety biology glass slides plastic boxes from 100% factory
- Category:
- Supplier: Xinxiang,Vic,Science,&,Education,Co.,Ltd.,[Henan,China]Xinxiang
RUB 37.17 - RUB 557.46
In Stock

for sale prepared microscopic plastic prepared slides box microscope slide box
- Category:
- Supplier: Xinxiang,Vic,Science,&,Education,Co.,Ltd.,[Henan,China]Xinxiang
RUB 52.03 - RUB 111.50
In Stock
